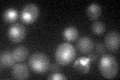
YFL044C
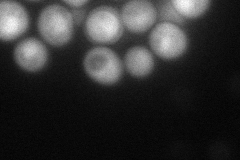
YFL044C
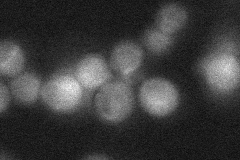
YFL044C

View description
Deubiquitylation enzyme that binds to the chaperone-ATPase Cdc48p; may contribute to regulation of protein degradation by deubiquitylating substrates that have been ubiquitylated by Ufd2p; member of the Ovarian Tumor (OTU) family
Localization:
Intensity:
Fold change:
Significance:
-
C’ GFP library in SD
nucleus23.33 -
N' NOP1pr-GFP in SD
cytosol,nucleus0 -
N' TEF2pr-mCherry in SD

missing0 -
N' NATIVEpr-GFP in SD
cytosol28.78 -
N' TEF2pr-VC and Cyto-VN in SD

#N/A0 -
C’ GFP library in SD+DTT

nucleusN/AN/AYes -
C’ GFP library in SD+H2O2

nucleusN/AN/AYes -
C’ GFP library in Starvation Media

technical problem0N/AYes -
C’ GFP library on the background of Pup2-DaMP

N/A -
C’ GFP library on the background of CCT mutant

N/A0N/AYes
